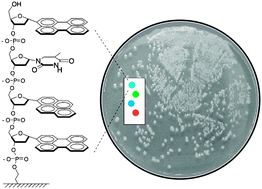

Polyfluorophores built on a DNA scaffold (ODFs) were synthesized and tested for fluorescence responses to the volatiles from M. tuberculosis, E. coli and P. putida in closed Petri dishes. Two sensors in a pattern-based response could distinguish the bacterial strains accurately, suggesting the use of ODFs in rapid identification of infectious agents.